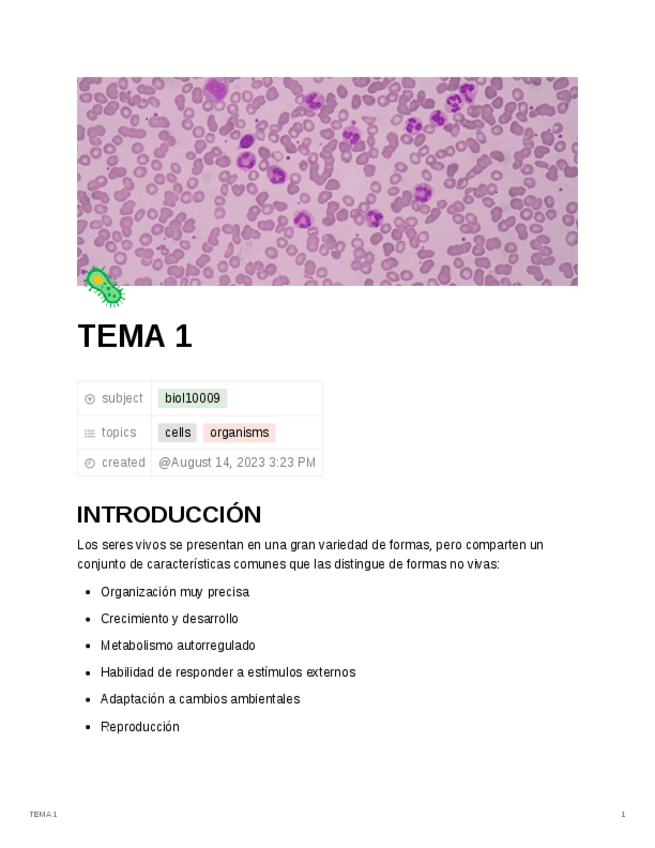

@farmapUVntes
Bio: Apuntes de la carrera, exámenes...
65 Publicaciones
1.17k Interacciones
20 Seguidores
18 Siguiendo
Lista de publicaciones de farmapUVntes
He publicado nuevos apuntes de 3º Nutrición y Bromatología: Seminario-ejercicios-practicas.pdf
apuntes
-
TUTORÍAS
He publicado nuevos apuntes de 3º Nutrición y Bromatología: TUTORÍAS
He publicado nuevos practicas de 3º Nutrición y Bromatología: FICHAS-LAB-2025.pdf
apuntes
-
TÉRMINOS
He publicado nuevos apuntes de 3º Fisiopatología: TÉRMINOS
He publicado nuevos ejercicios de 2º Análisis Químico: EJERCICIOS-TEMA-7.pdf
He publicado nuevos apuntes de 2º Microbiología: Otros-generos-bacterias.pdf
He publicado nuevos apuntes de 2º Microbiología: Bacteriastablaotrosgeneros.pdf
He publicado nuevos apuntes de 2º Microbiología: EJERCICIO-PCR-CASANOVA.pdf
apuntes
-
ANÁLISIS
He publicado nuevos apuntes de 2º Análisis Químico: ANÁLISIS
apuntes
-
Microbiología
He publicado nuevos apuntes de 2º Microbiología: Microbiología
apuntes
-
Fisiología Vegetal
He publicado nuevos apuntes de 1º Fisiología Vegetal: Fisiología Vegetal
He publicado nuevos practicas de 1º Anatomía Humana: EMBRIOLOGIA-E-HISTOLOGIA.pdf
examenes
-
EXÁMENES QG
He publicado nuevos examenes de 1º Química General: EXÁMENES QG
apuntes
-
Química General
He publicado nuevos apuntes de 1º Química General: Química General
He publicado nuevos apuntes de 1º Biología General: BIOLOGIA-GENERAL-APUNTES-COMPLETOS.pdf
apuntes
-
Biología General
CASTELLANO
apuntes
-
ESTADÍSTICA
Gr.E
apuntes
-
FÍSICA
CASTELLANO